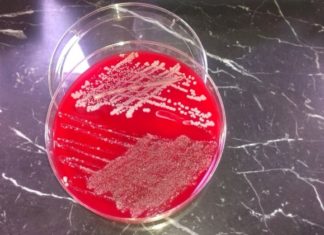
Mbani mend: Këto janë simptomat më të zakonshme të infeksionit me stafilokok

Simptomat e inflamacionit të mushkërive
Inflamacioni i mushkërive mund të shfaqet tek të gjithë, pasiqë bëhet fjalë për komplikimin më të zakonshëm të sistemit të frymëmarrjes, dhe sidomos të gripit. Megjithëse shpesh është pasojë e disa infeksioneve, ekzistojnë më...
Sinjalet që na i dërgon trupi: Këto 4 probleme paralajmërojnë mungesën e vitaminave!
Vitaminat dhe mineralet janë të nevojshme për funksionimin normal të trupit, por nëse keni mungesë të ndonjërës atëherë trupi do t'ju dërgoj sinjale të qarta. Shpesh është e mjaftueshme që vetëm të dëgjojmë organizmin...
Dhimbja në këtë pjesë të trupit shpesh zbulon sëmundje progresive
Kërdhokulla është nyja më e madh në trupin e njeriut, por kur shfaqen dhimbje, shumë njerëz nuk kërkojnë ndihmë mjekësore. Por dhimbja në këtë pjesë të trupit është një nga simptomat më të zakonshme...
Shëndeti i zorrëve – kyç për shëndetin e të gjithë organizmit
Numri i neuroneve që gjenden në zorrë është më i madh se numri i neuroneve që gjenden në kokë, thotë Dr. Alejandro Junger dhe zbulon se shumë sëmundje janë pasojë e dëmtimit të zorrëve.
Pak...
Katër hapa për një stomak të shëndetshëm
Nuk është e rëndësishme që stomaku të jetë vetëm "i sheshtë" dhe i shtrënguar. Është shumë më e rëndësishme që të jetë i shëndetshëm, pasi që kjo gjë shpesh harrohet pasi njerëzit fokusohen vetëm...
Mbani mend: Këto janë simptomat më të zakonshme të infeksionit me stafilokok
Bakteret e stafilokokut jo gjithmonë janë vdekjeprurëse dhe të rrezikshme, por sipas Dr. Philippe Faye, drejtorë i mjekësisë në Universitetin e Nebraskës, këto baktere janë mjaft miqësore për të jetuar në trupin tonë pa shkaktuar...
Mos e injoroni inflamacionin e fshikëzës
Inflamacioni i fshikëzës ose i njohur ndryshe si infeksion i traktit të poshtëm urinar mund të prekë të dyja gjinitë, por gratë janë më të prirura ndaj këtij problemi shëndetësor, i cili di të...
Cilat janë simptoma që tregojnë kancerin e gjirit tek meshkujt?
Përderisa, mesatarisht një në tetë gra vuan nga kanceri i gjirit, kjo sëmundja do të diagnostikohet tek një nga 870 meshkuj. Megjithëse, kryesisht i prek njerëzit më të vjetër se 60 vjeç, në raste...
Simptomat e dëmtimit të mëlçisë
Mëlçia është organ i cili ka një rol shumë të rëndësishëm metabolik. Ai kryen disa funksione, ndër të cilat më të rëndësishmet janë detoksifikimi, anulimi i glikogjenit dhe prodhimi i proteinave në gjak. Mëlçia...
Sulmi i zemrës gjithnjë më i zakonshëm tek gratë e reja
Mendimi se sulmi në zemër (infarkti i miokardit) është sëmundje e meshkujve të moshuar nuk është më i vlefshëm, duke pasur parasysh rezultatet e studimi të kohëve të fundit, i cili tregon se sulmi...